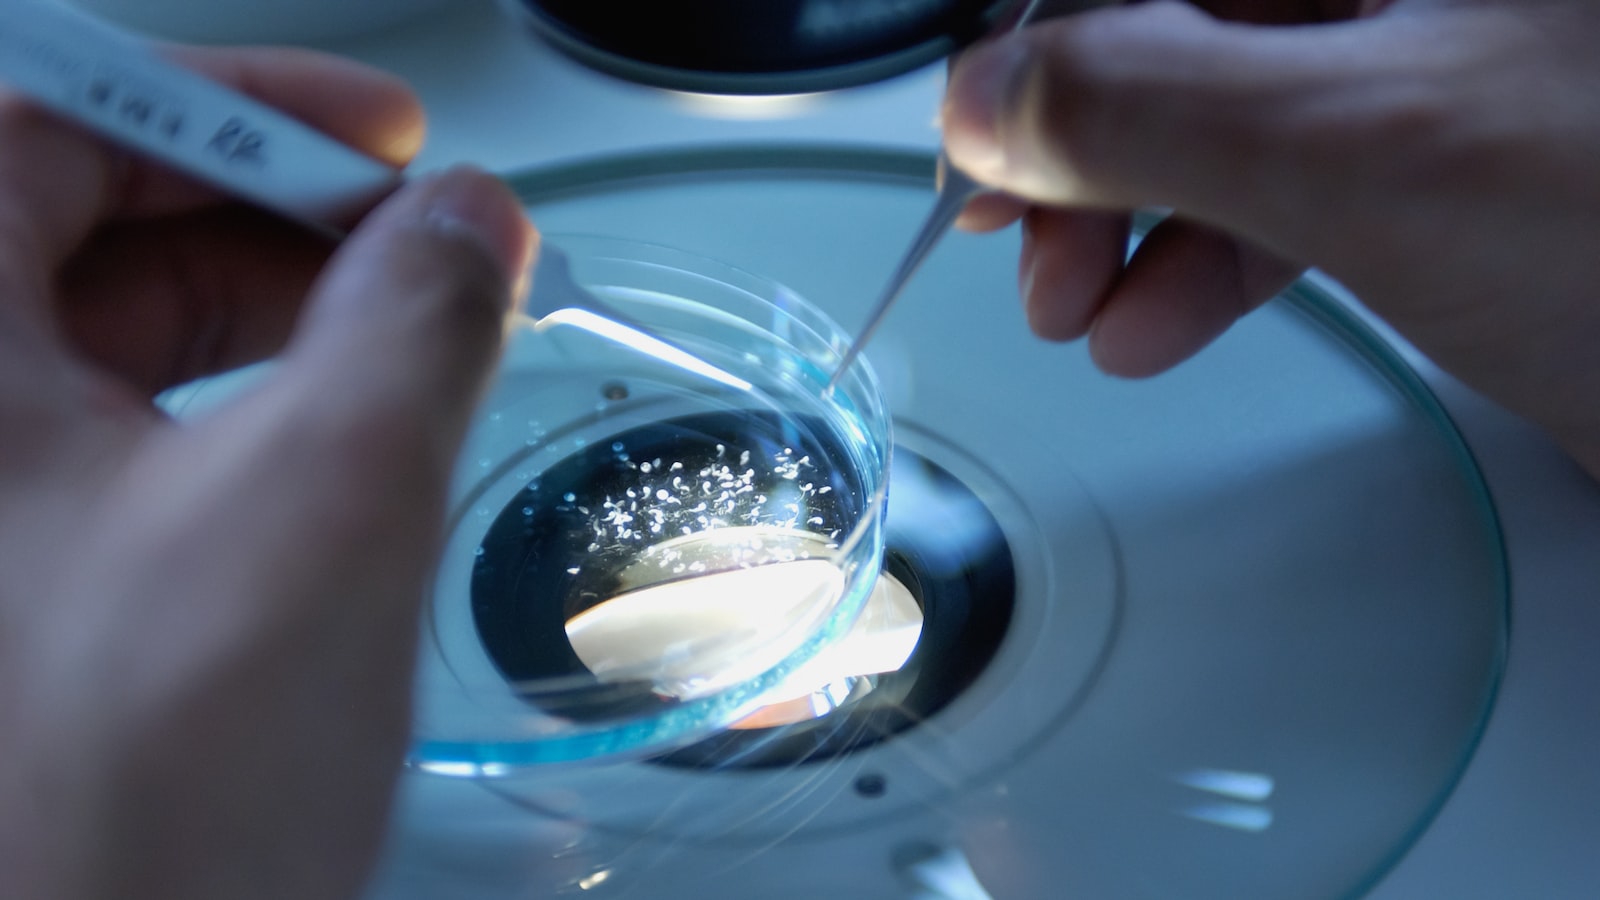

산부인과학과 비뇨기과학의 의학적 특징
산부인과학의 의학적 특징
산부인과학은 여성의 생식기관과 유방, 임신, 분만, 여성의 비뇨기 질환에 관련된 질병을 다루는 의학 전문 분야입니다. 이 분야는 여성의 건강과 웰빙에 중점을 두고 연구되며 여성의 생리학적 특성과 질환이 분석됩니다.
산부인과학은 산후기 관리, 배란 및 생식 기능 장애, 여성 생식기 질환, 임신 중 장애, 생식 불능, 생리주기 및 원발성 및 이차성 생식기 종양 관리 등에 대한 의료 서비스를 제공합니다. 이 분야는 개인적이고 민감한 주제를 다루기 때문에 의사는 대개 이 분야에 대해 특별한 훈련을 받아야 합니다.
비뇨기과학의 의학적 특징
비뇨기과학은 비뇨기계와 남성 생식기계 질환을 전문적으로 다루는 의학 분야입니다. 비뇨기과 전문의는 요로계를 포함한 신장, 방광, 요도, 요실금, 남성 생식기계 등의 기능 및 질환에 대한 지식과 전문 기술을 보유하고 있습니다.
비뇨기과학은 다양한 질병과 증상을 다루지만, 가장 흔한 것은 방광과 신장같은 비뇨기계의 문제입니다. 이러한 문제는 독특하게 동작하는 비뇨기계를 다양한 외부 병리학적인 영향으로 인해 발생할 수 있습니다. 비뇨기과는 비뇨계 질환, 반복성 방광염, 남성 생식기 질환, 요도 결석 및 요관 폐쇄 등을 다룹니다.
산부인과학과 비뇨기과학의 연관성
산부인과학과 비뇨기과학은 서로 연결되어 있습니다. 여성은 생식기와 비뇨계를 함께 가지고 있기 때문에 이 두 분야는 밀접한 관련성을 가지고 있습니다. 다양한 생리학적인 요소, 예를 들어 임신과 출산, 여성의 해부학적 고유성, 비뇨기계의 해부학적 구조는 이 교차 분야에 영향을 미칠 수 있습니다.
산부인과학과 비뇨기과학은 여성의 생식기와 비뇨기계 질환의 진단과 치료에 대한 종합적인 접근 방법을 제공합니다. 두 분야의 전문가들은 종종 함께 협력하여 여성의 건강과 웰빙을 개선하는 데 도움이 됩니다.
산부인과학과 비뇨기과학 의사의 영역
산부인과학과 비뇨기과학 의사는 각각의 분야에서 폭넓은 지식과 임상 경험을 갖추고 있습니다. 산부인과학 의사는 여성의 비뇨기계 질환, 생식기 질환, 임신 및 출산 관련 학문과 기술을 다루며, 비뇨기과학 의사는 비뇨기계와 남성 생식기계 질환에 대한 지식과 기술을 갖추고 있습니다.
두 분야의 의사는 종종 연구 및 임상 시행을 통해 지속적인 전문 교육을 받으며 최신의 의학 지식을 익히고 있습니다. 이러한 전문성과 지식은 환자들에게 정확하고 개인 맞춤형 치료 방법을 제공하는 데 도움이 됩니다.
정리
산부인과학과 비뇨기과학은 여성의 건강과 웰빙을 위해 중요한 의학 분야입니다. 이러한 진료 분야에서는 정확한 진단과 치료를 위해 전문적인 의료진의 도움이 필요합니다. 이러한 분야에서 활동하는 의사들은 각각의 전문 분야에 대한 폭넓은 경험과 지식을 가지고 있으며, 연구와 교육을 통해 최신의 의학 지식을 활용하고 있습니다.
산부인과학과 비뇨기과학은 여성들의 건강과 질병 예방을 위해 중요한 역할을 합니다. 이러한 분야의 의사는 환자의 필요와 상황에 맞게 개인 맞춤형 만족스러운 의료 서비스를 제공하기 위해 노력하고 있습니다.
이 블로그 게시물은 산부인과학과 비뇨기과학의 의학적 특징에 대한 개괄적인 내용을 제공하여 두 분야에 대한 이해를 돕기 위해 작성되었습니다.
'의학상식' 카테고리의 다른 글
| 겸상적혈구빈혈증의 원인과 증상 및 치료법 (1) | 2023.11.08 |
|---|---|
| 피부과학의 의학적 특징 알아보기 (0) | 2023.11.04 |
| 내분비학의 의학적 특징 알아보기 (0) | 2023.11.04 |
| 비뇨기과학과 신장학의 의학적 특징 (0) | 2023.11.04 |
| 안과학과 이비인후과학의 의학적 특징 (0) | 2023.11.03 |